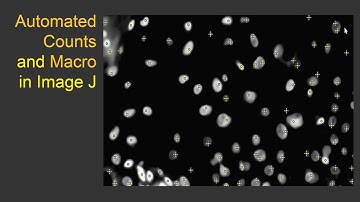
Counts in ImageJ

⬇ DOWNLOAD NOW
Jika muncul iklan pop-up, tutup lalu klik tombol kembali
Download lagu How to show images with the same display values in ImageJ secara gratis hanya untuk keperluan promosi. Dukung artis favorit kamu dengan membeli musik original di iTunes atau platform resmi lainnya.
 Area Fraction using ImageJ
Area Fraction using ImageJ Making annotated videos of data with Fiji
Making annotated videos of data with Fiji How to increase image pixel size and resolution using ImageJ Software
How to increase image pixel size and resolution using ImageJ Software Crop multiple images at the same site using ImageJ
Crop multiple images at the same site using ImageJ Counts in ImageJ
Counts in ImageJ How to enhance fluorescence intensity in imageJ | Confocal images not showing fluorescence in imageJ
How to enhance fluorescence intensity in imageJ | Confocal images not showing fluorescence in imageJ How to use ImageJ software to count Cell numbers, analyze Area and the Intensity
How to use ImageJ software to count Cell numbers, analyze Area and the Intensity Showing how to create overlay with original image in ImageJ
Showing how to create overlay with original image in ImageJ